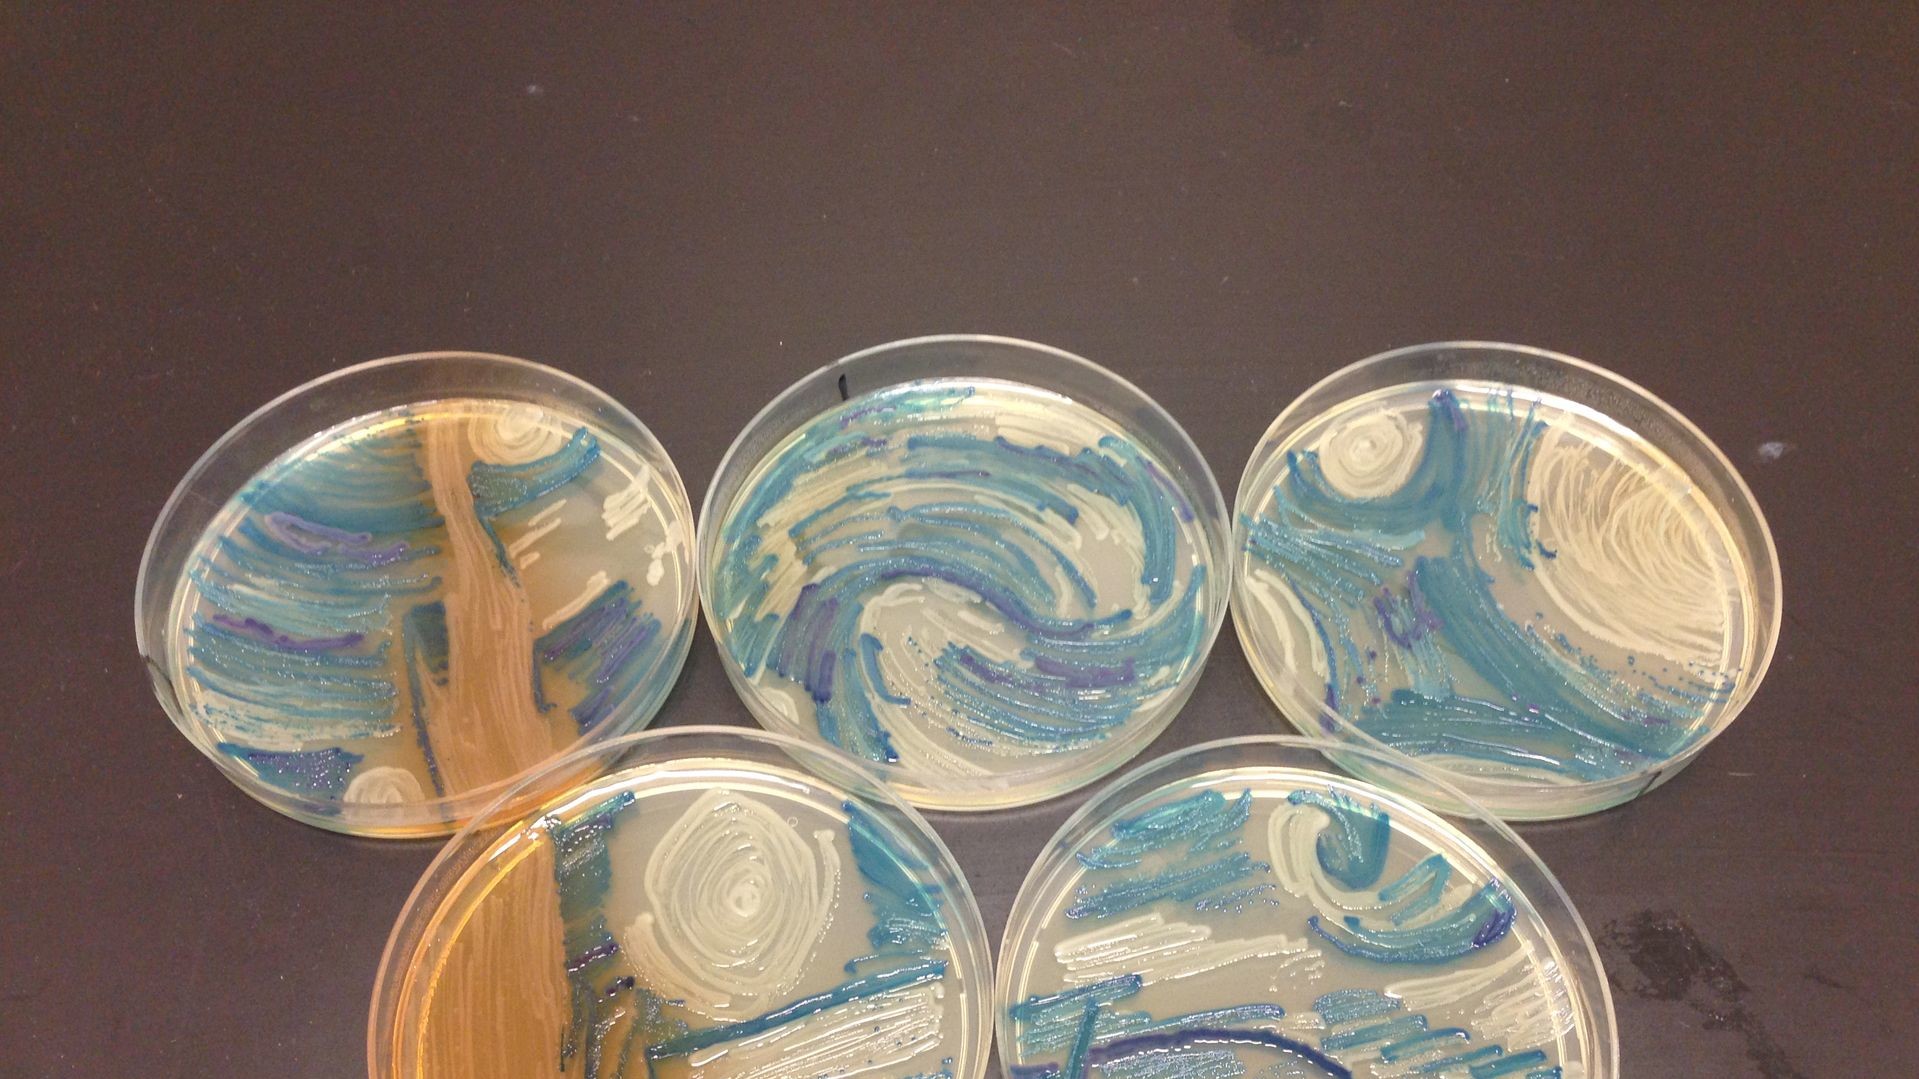
"Зоряна ніч"
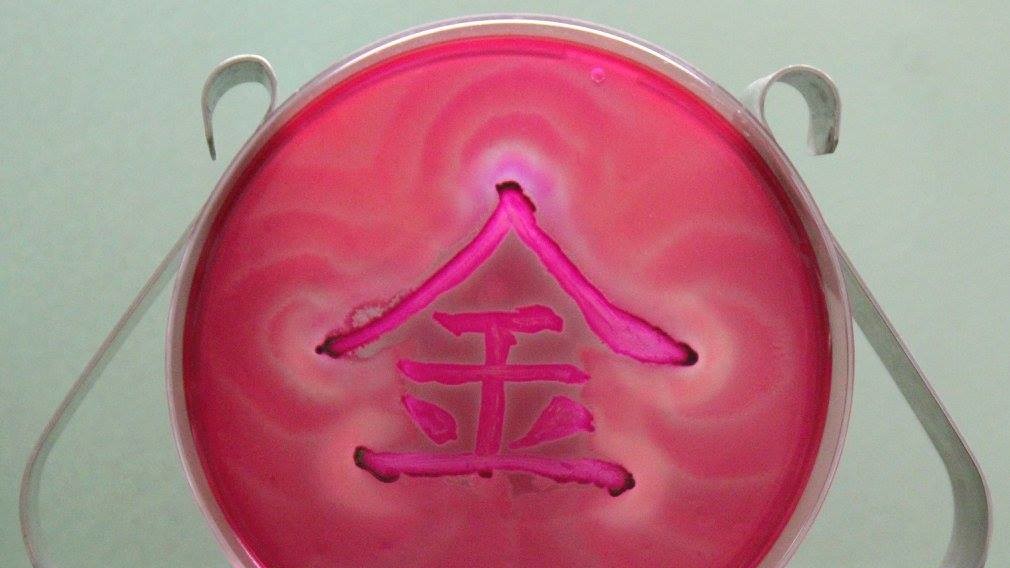
Картини з бактерій

На конкурс Американського співтовариства мікробіологів First Agar Art Contest вчені подали картини, створені з бактерій. В якості полотна використовувалася чашка Петрі, наповнена живильним середовищем з агар-агару, а в якості фарб – колонії бактерій.
Перше місце в конкурсі дісталося Марії Пенил. З допомогою бактерій вона зобразила нейрони.
Нещодавно українські вчені в чашці Петрі створили портрет Мони Лізи з мікробів методом фотоперемикання.

Увійти за допомогою Google
Увійти за допомогою Google